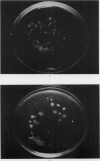
430-1

Full text
PDF

















Images in this article
Selected References
These references are in PubMed. This may not be the complete list of references from this article.
- ARRIAGADA A., SAVAGE M. C. Ayfivin; an antibiotic from B licheniformis; production in potato-dextrose medium. Br J Exp Pathol. 1949 Oct;30(5):425–427. [PMC free article] [PubMed] [Google Scholar]
- Markham R. A steam distillation apparatus suitable for micro-Kjeldahl analysis. Biochem J. 1942 Dec;36(10-12):790–791. doi: 10.1042/bj0360790. [DOI] [PMC free article] [PubMed] [Google Scholar]
- SHARP V. E., ARRIAGADA A. Ayfivin; extraction, purification, and chemical properties. Br J Exp Pathol. 1949 Oct;30(5):444–457. [PMC free article] [PubMed] [Google Scholar]